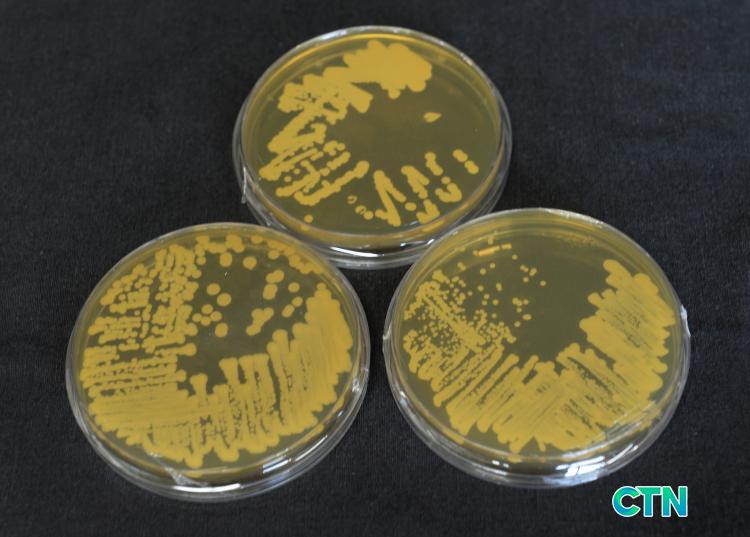

|
οҿ 2015 2017 3Ⱓ Ǵ ǰ ڿ ȿκ ȿ 3,956 Ͽ ȿ ڿ , , ⼺ м ߰ 5 ߴ.
ʿ Ư 1 2019 6 Ͽ ̹ Ư Ϸ ȿ õ Ȯϰ ̴.
ȿ ȿ ݵ ʿ ̻μ , , ִ ߿ ϸ ǵǴ ȿ Ի κ ̸ ü ȿ ñ ̾.
ݹ ϵ Ư ִ ǰ ڿ ȿ ȭ ȿ ַ ɼ Ͽ Ȱ뵵 ſ ȴ.
̿ Ҿ 2020 ߵǾ ִ ȿ ҷκ ̳ʸ 3Ҵ ȿ Ư ſ Ÿ. ̷μ 츮 ȭ ߱ϴ ̳ʸ Ȱ ȴ.
ο "̹ Ư Ȯ ' ȿ ' иȭ ߰ Ȯ Ӹ ƴ϶ ο Ͽ ̳ʸ Ǵ ű ϰڴ." ߴ.
ö pro861@hanmail.net
2026.03.06() 01:15
Ÿ Ź